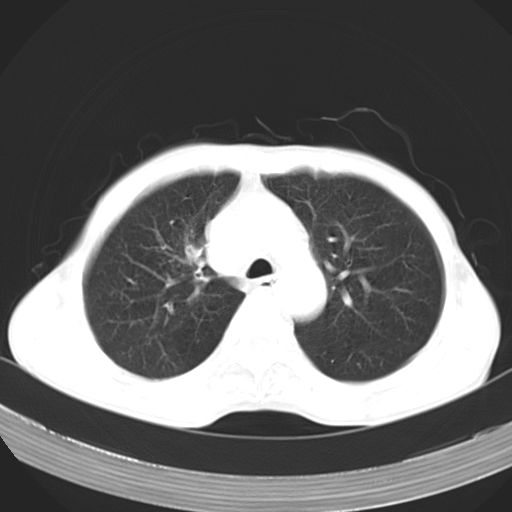

以下是引用zhangzhongshou在2007-5-24 12:55:00的发言:[br]1、右肺中叶中心型肺癌并右肺门、隆突下、纵隔淋巴结转移。右肺中叶阻塞性肺炎。
以下是引用zhangzhongshou在2007-5-24 12:55:00的发言:[br]1、右肺中叶中心型肺癌并右肺门、隆突下、纵隔淋巴结转移。右肺中叶阻塞性肺炎。
以下是引用苯小孩在2007-5-24 12:47:00的发言:[br]右侧肺门处不均匀密度软组织块影,远端肺组织见斑片模糊影,纵隔内淋巴结明显肿大,边界不清.<纵隔窗第12层面支气管内似见软组织结节>[br]考虑:1、右侧中央性肺癌并阻塞性肺炎并纵隔淋巴结转移可能性大.建议强化或纤支镜进一步检查.[br]2、隆突下淋巴结肿大/食道病变?请做鉴别检查.
以下是引用zhangzhongshou在2007-5-24 12:55:00的发言:[br]1、右肺中叶中心型肺癌并右肺门、隆突下、纵隔淋巴结转移。右肺中叶阻塞性肺炎。

以下是引用jw-830在2007-5-24 15:24:00的发言:[br][br] [br] 考虑右肺中央型肺癌并阻塞性炎症,右肺门及纵隔淋巴结转移。 [br] [br][br]
| 欢迎光临 医影在线 (http://bbs.radida.com/bbs/) | Powered by Discuz! X3.2 |